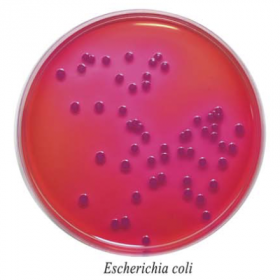
Агар Мосселя

Агар Мосселя
Агар Мосселя сухой
Для проведения бактериологического исследования клинического и другого материала с целью получения дополнительной информации о состоянии и клинической ситуации при диагностике заболеваний, вызванных энтеробактериями.
Данный продукт имеет Регистрационное Удостоверение.
Фасовка 250 г для пиготовления 5,7 л среды.
Срок годности 2 года.
- Стерильность: -
- Форма выпуска: Порошок
- Упаковка: 250 г
- Документы: Регистрационное Удостоверение